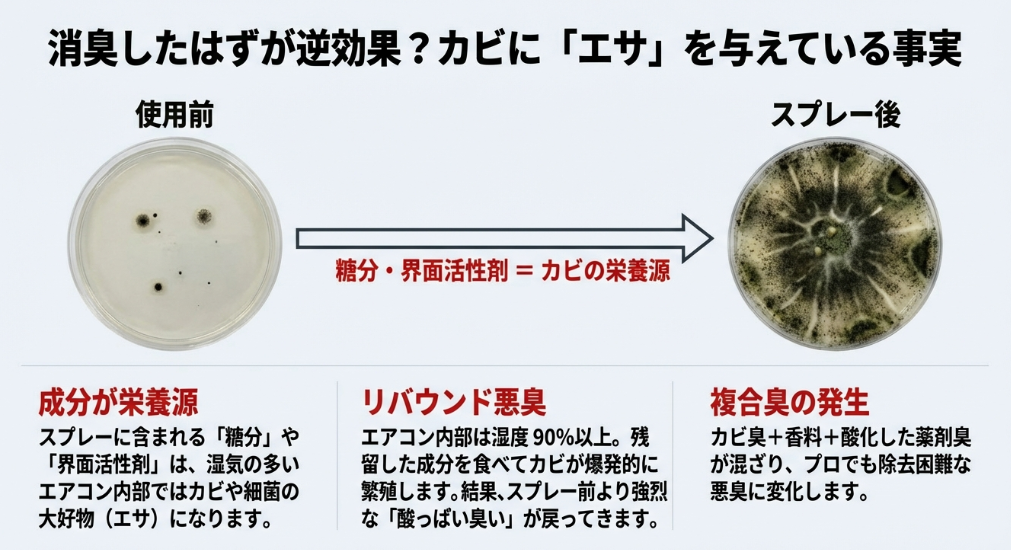
シャーレ内でのカビの増殖比較画像。スプレーの糖分や界面活性剤によりカビが爆発的に繁殖し、悪臭が戻る様子

こんにちは。リライフです。
エアコンをつけた瞬間、酸っぱい臭いやカビ臭い風が漂ってくると、本当に気分が沈んでしまいますよね。来客前や就寝時など、今すぐどうにかしたいという時、つい手元にあるファブリーズなどの布用消臭スプレーを吹き出し口にシュッとしたくなる気持ち、よく分かります。
しかし、良かれと思ってやったその行動が、実はエアコンの故障の原因になったり、最悪の場合は火災のリスクを招いたりすることをご存知でしょうか。ダイキンの警告やNITEによる注意喚起でも、エアコン内部への不用意なスプレー噴射は厳禁とされています。
この記事では、なぜエアコンの臭い対策にファブリーズを使ってはいけないのか、そしてカビの繁殖を抑えて安全に臭いを消すにはどうすればいいのか、私たちが現場で培った知識をもとにお伝えします。
- 布用消臭剤がエアコン内部の金属やプラスチックに与える致命的なダメージ
- スプレー成分がカビの餌になり、かえって臭いが悪化してしまうメカニズム
- 製品評価技術基盤機構(NITE)も警告する、電装部のショートや発火の危険性
- 業者に頼まず今すぐ実践できる、安全で効果的な「16度冷房」などの応急処置
そのスプレー、
カビの餌(エサ)になっていませんか?
自己流の消臭スプレーは、エアコン内部で「カビの栄養源」になり、
かえって悪臭を悪化させる原因になります。
取り返しのつかない故障や火災を招く前に、
まずはプロの視点で「臭いの元凶」を診断させてください。
エアコンの臭いにファブリーズを使うのが危険な理由
エアコンから嫌な臭いがしてくると、つい「除菌・消臭」と書かれたスプレーを頼りたくなりますが、そこには大きな落とし穴があります。まずは、なぜ布用製品を家電に使うのが危険なのか、その理由を詳しく見ていきましょう。
吹き出し口へのスプレーは故障の原因になります

エアコンの吹き出し口からスプレーを噴射すると、ミスト状の液体が内部の精密部品に直接かかってしまいます。特に送風ファンやその奥にあるモーター、各種センサー類は非常にデリケートです。
布用消臭剤に含まれる界面活性剤や香料は、ベタつきを残しやすく、これが回転部に付着すると負荷がかかってモーターの異音や故障を招くことがあります。また、温度を検知するセンサーに液体が付着すると、正確な室温管理ができなくなり、「冷えない」「暖まらない」といったトラブルに直結してしまいます。
精密機械としてのエアコンの弱点
エアコンの内部は、私たちが想像している以上に精密な電子制御が行われています。吹き出し口のすぐ奥には、冷たい風を送り出すための「シロッコファン」が高速で回転していますが、ここに粘着性のある消臭成分が付着するとどうなるでしょうか。ファンのバランスが崩れ、軸受けに過度な負担がかかることで、ガタガタという異音が発生するようになります。一度異音が出始めると、部品交換以外に直す方法はありません。
センサー類の誤作動リスク
さらに深刻なのがセンサーへの影響です。エアコンには吸い込み温度や湿度を測るサーミスタという部品が各所に配置されています。スプレーのミストがこれらの表面を覆ってしまうと、センサーが正確な数値を読み取れず、部屋が十分冷えているのにフルパワーで運転を続けたり、逆に全く冷えなくなったりします。
こうした「目に見えない故障」は原因特定が難しく、最終的にメーカーの出張修理を呼ぶことになり、数万円の痛い出費に繋がってしまうこともあるんですね。
ダイキンなど大手メーカーが使用を禁止する背景
ダイキンやパナソニック、三菱重工といった主要なエアコンメーカーは、取扱説明書や公式サイトで、市販の洗浄スプレーや消臭剤の使用を控えるよう明記しています。これは、エアコンの心臓部である「熱交換器(アルミフィン)」に施されている特殊なコーティングを、スプレーの成分が剥がしてしまう恐れがあるからです。
コーティングが剥がれると、結露水がうまく流れずに水漏れの原因になったり、アルミが腐食してガス漏れを引き起こしたりと、修理に数万円かかる致命的なダメージにつながることも珍しくありません。
熱交換器の「親水性コーティング」の役割
エアコンのアルミフィンには、結露した水滴が玉にならずに、スッと流れ落ちるように「親水性コーティング」というものが施されています。ファブリーズなどの布用スプレーに含まれる特定の界面活性剤や溶剤は、このコーティングを溶かしたり、性質を変えてしまったりする性質があります。
コーティングが機能しなくなると、水滴がフィンに留まり、風が通る道を塞いでしまう「目詰まり」が発生します。これが「風が弱くなった」「冷えが悪くなった」と感じる大きな要因の一つです。
アルミ腐食とガス漏れの恐怖
アルミニウムは非常にデリケートな金属で、酸性やアルカリ性の液体に触れると簡単に腐食(サビ)が進みます。布用スプレーの成分がフィンの隙間に残留し続けると、じわじわとアルミを腐食させ、白い粉状のサビ(白サビ)を発生させます。
これがさらに進んで、内部を通る銅管にピンホール(微細な穴)を開けてしまうと、冷媒ガスが漏れ出してしまいます。ガス漏れの修理は非常に高額で、場合によっては新品を買い替えたほうが安上がりという状況にもなりかねません。
メーカーの立場:
メーカーが「禁止」と言っているのには、それなりの理由があります。万が一、禁止されている方法で掃除を行い故障した場合、保証期間内であっても有償修理になる可能性が極めて高いことを覚えておきましょう。
自分で掃除をすると火災リスクが高まるメカニズム

最も恐ろしいのが、電気系統への影響です。製品評価技術基盤機構(NITE)の調査では、エアコン内部の電装部に洗浄液や消臭剤が侵入することで発生する火災事故が報告されています。
「トラッキング現象」と呼ばれるこの現象は、基板についた液体とホコリが混ざり合って電気が流れる道を作ってしまい、ある日突然ショートして発火するものです。スプレーをした直後ではなく、数週間から数ヶ月後に発生することもあるため、非常に予測が難しく危険な「時限爆弾」のような状態になってしまいます。
トラッキング現象の仕組み
エアコンの右側にある電装ボックスには、細かな端子が密集した基板が入っています。本来、電気は決められた回路を通りますが、液体成分が基板に付着すると、その水分や電解質を介して、本来流れてはいけない場所に電気が漏れ出します。
これが繰り返されると、絶縁体であるはずの部分が熱で炭化し、電気が通りやすい「炭の道(トラック)」ができてしまいます。こうなると、スイッチがオフの状態であっても火花が飛び、周囲のプラスチック部品に燃え広がってしまうのです。
NITEによる注意喚起
実際に、不適切な洗浄による火災事故は毎年のように発生しています。独立行政法人製品評価技術基盤機構(NITE)の発表によると、内部洗浄の際の洗浄液の付着が原因で、多くの重大事故が報告されています。 (出典:独立行政法人製品評価技術基盤機構(NITE)『エアコン掃除での事故に注意』) このように、命に関わるリスクがある以上、安易にスプレーを吹きかけるのは絶対に避けるべき行為と言えます。
消臭成分がカビの餌になり、逆効果を招きます
ファブリーズなどの成分には、トウモロコシ由来の消臭成分(シクロデキストリン)が含まれていることがあります。布地であれば乾いて消臭してくれますが、湿気の多いエアコン内部では、この糖分や界面活性剤がカビや細菌にとって絶好の栄養源になってしまいます。
一時的に香料で臭いが消えたように感じても、数日後にはさらに強力に増殖したカビによって、以前よりもひどい「酸っぱい臭い」が発生するという悪循環に陥ってしまうのです。まさに、生ゴミに香水をかけて放置しているような状態と言えるでしょう。
カビの「リバウンド現象」
布用消臭剤の多くは、成分を対象物に残留させることで効果を発揮します。しかし、エアコン内部は冷房使用時に湿度が90%以上にも達する環境です。残留した糖由来の成分や界面活性剤は、カビにとって最高の御馳走になります。一度死滅したかに見えたカビも、これらの栄養を得ることで、以前よりも爆発的な勢いで繁殖を始めます。これが、スプレーをした数日後に、以前よりも強烈な「雑巾のような臭い」が戻ってくる理由です。
複合臭によるさらなる悪化
さらに厄介なのが、カビが発生させる「カビ臭」と、消臭スプレーの「香料」、そして古くなって酸化した「薬剤の臭い」が混ざり合うことです。この複合臭は、通常のエアコンクリーニングでも一度では落としきれないほど強烈なものになることがあります。私たちが現場で見かける「最悪のケース」は、まさにこのパターンです。安易な消臭対策が、結果としてプロの手でも解決困難なほどの深刻な事態を招いてしまうことがあるのです。
賃貸物件で勝手に使うと修繕費用の全額負担も発生

賃貸住宅にお住まいの場合、備え付けのエアコンを誤った方法で故障させてしまうと、「善管注意義務違反」に問われる可能性があります。通常の使用による経年劣化であれば大家さんの負担で修理されますが、市販のスプレー使用による故障は借主の過失とみなされ、数万円の修理費や、最悪の場合は新品への交換費用を全額請求されるリスクがあります。退去時のトラブルを避けるためにも、自己流のメンテナンスには細心の注意が必要です。
善管注意義務とは何か
賃貸借契約において、借主には「善良な管理者の注意をもって建物を管理する義務」があります。簡単に言えば、「借り物なんだから丁寧に扱ってね」ということです。メーカーが禁止している方法で掃除をすることは、この義務に反すると判断される可能性が高いです。
特にエアコン内部にスプレーした跡(ベタつきや薬剤の色など)は、専門の業者が内部を見れば一発で分かってしまいます。故意ではなくても、正しい知識を持たずに行った行為が、法的な責任を問われるきっかけになるのです。
退去時のトラブルを防ぐために
退去時の立ち会いでエアコンの不具合や異臭、内部の腐食が指摘された場合、その原状回復費用として高額な請求が来るケースがあります。最近は賃貸管理会社もこうしたDIYによる故障を警戒しています。「ちょっとした掃除のつもりだった」という言い訳は通用しません。もし現時点で既にスプレーを使ってしまい、不安を感じている場合は、早めにプロのクリーニングを入れ、内部を正常な状態に戻しておくことを強くおすすめします。
賃貸でのエアコン清掃やカビ対策については、こちらの記事も参考にしてみてください。
エアコンのカビは気にしすぎ?プロが教える真実
エアコンの臭いをファブリーズ以外で解消する対策
「じゃあ、この臭いはどうすればいいの?」とお困りの方へ。プロも認める、安全かつ効果的な対処法をステップ別にご紹介します。まずは機械に負担をかけない方法から試してみましょう。
即効性を求めるなら16度の冷房運転が有効です

今すぐ臭いを軽減したい時に最も安全な方法は、窓を全開にした状態で「設定温度を16度(最低温度)」にして、1時間ほど冷房運転をすることです。
これにより、熱交換器に大量の結露水が発生し、アルミフィンに付着した臭い成分や軽い汚れを洗い流してドレンホースから排出してくれます(簡易的なセルフ洗浄)。運転が終わった後は、内部をしっかり乾かすために「内部クリーン」や「送風運転」を1時間ほど行うのを忘れないでください。これだけでも、一時的な臭いの強さはかなり改善されるはずです。
なぜ「16度」で臭いが取れるのか
エアコンの臭いの原因となる物質の多くは、水に溶けやすい性質を持っています。設定温度を最低にすると、エアコンは室温との差を埋めようとして全力で冷やし始め、アルミフィンに大量の結露水がびっしりと付きます。この「天然の水」が、洗剤を使わずに汚れを浮かせ、ドレンパンから屋外へと流してくれるのです。この方法はメーカーのエンジニアも推奨することがある、非常に合理的で安全な「セルフクリーニング」術なんですよ。
換気を忘れずに行うことが重要
この作業を行う際は、必ず部屋の窓を全開にしてください。せっかく内部から洗い流された臭い成分が、空気中に放出された後にまたエアコンに吸い込まれてしまっては意味がありません。空気を常に入れ替えながら運転することで、室内の臭気濃度を下げ、効率的に脱臭することができます。もし、1時間経っても改善が見られない場合は、汚れが既に水流だけでは落ちない「こびりつき」になっている証拠です。
市販の洗浄剤の代用では奥の汚れまで届きません

ホームセンターなどで売られている「エアコン洗浄スプレー」も、実はあまりおすすめできません。スプレーの圧力では、厚みのある熱交換器の表面しか洗えず、逆に汚れを奥に押し込んで目詰まりを悪化させてしまうことが多いからです。
また、洗剤成分が内部に残ってしまうと、それが再びカビの餌やベタつきの原因になります。プロの洗浄と決定的に違うのは、「大量の水で完全にすすぎ流せるかどうか」という点です。中途半端な洗浄は、かえってエアコンの寿命を縮めてしまう結果になりかねません。
洗浄スプレーの圧力不足と「汚れの押し込み」
エアコンの熱交換器は、厚みが数センチメートルある何層ものフィンで構成されています。市販のスプレー缶の圧力は、せいぜい表面のホコリを湿らせる程度。汚れを「除去」するのではなく、フィンの隙間の奥へと「移動」させているだけに過ぎないのです。奥に押し込まれた汚れは空気の通り道を塞ぎ、エアコンの効率を著しく低下させます。これが原因で「洗ったのに風が弱くなった」というトラブルが頻発しています。
「すすぎ」ができない致命的な欠点
最大の懸念事項は、洗剤成分を洗い流す「すすぎ」の工程が欠落していることです。プロのクリーニングでは、専用の薬剤を使った後、大量の(10リットル以上)水で徹底的にすすぎます。スプレー缶の場合、その後に発生する結露水で流れるとされていますが、その程度では全く不十分です。
残った洗剤は乾燥して固まり、新たなホコリをキャッチし、最終的にはカビの温床となります。結局、自分でする洗浄は「将来のカビを予約している」ようなものかもしれません。
根本的に解決したいなら専門業者への依頼が最適

もし、16度運転をしても臭いが消えない、あるいは吹き出し口の中に黒い点々(カビ)が見える場合は、内部に「バイオフィルム」と呼ばれるヘドロ状の汚れが溜まっています。
これはプロの道具を使わない限り、落とすことは不可能です。専門業者はエアコンを分解し、電装部を完璧に養生した上で、高圧洗浄機を使って数リットルもの水と専用洗剤で奥の奥まで洗い流します。出てくる真っ黒な汚水を見れば、スプレーだけでは解決できなかった理由がひと目で納得できるはずです。
プロにしかできない「養生」と「分解」
エアコンクリーニングで最も重要なのは「洗うこと」以上に「守ること」です。基板やモーターに一滴の水も触れさせないよう、専門のビニールやマスキングテープを駆使した養生は、経験を積んだプロにしかできない技術です。また、ドレンパンや送風ファンを取り外して洗う「完全分解」に近い清掃を行えば、臭いの元凶であるヘドロを完全に除去できます。ここまでやって初めて、本当の意味での「清潔な空気」が戻ってくるのです。
高圧洗浄機の威力がカビを根こそぎ落とす
私たちが使用する高圧洗浄機は、スプレー缶とは比べ物にならない圧力で水を噴射します。この水流がフィンの隙間を突き抜け、裏側に張り付いたカビの胞子や油汚れを弾き飛ばします。バケツに溜まる真っ黒な水、そこには死滅したカビやダニの死骸、ハウスダストが凝縮されています。「これを吸っていたのか…」と驚かれるお客様は非常に多いですよ。健康を守るためにも、一年に一度の定期的なケアが理想的ですね。
パナソニック製などの精密機械はプロの技術で洗浄
近年のパナソニックやダイキンの「お掃除機能付きエアコン」は、内部構造が非常に複雑です。フィルターを自動で掃除するロボットユニットや、複雑な配線が張り巡らされており、素人が手を出すと元に戻せなくなったり、断線させたりするリスクが非常に高いです。リライフでは、これら複雑な機種の分解洗浄にも対応しており、10年以上の施工実績を持つスタッフが丁寧に作業を行います。最新機種こそ、メーカーの知識を持ったプロに任せるのが安心です。
「お掃除機能」を過信してはいけない理由
多くの人が誤解していますが、お掃除機能が掃除してくれるのは「フィルター」だけです。エアコン内部の熱交換器やファンに付着するカビまでは防げません。むしろ、お掃除ロボットという大きな部品が内部を覆っているため、通気性が悪くなり、通常モデルよりもカビが生えやすい傾向すらあります。お掃除機能付きだからといって安心せず、むしろ普通のエアコン以上に「中が汚れていないか」をチェックする必要があります。
複雑な分解難易度と専門知識
パナソニックなどの最新モデルは、お掃除ロボットを取り外すだけで30分以上かかることもあります。多くのコネクタやネジを適切に扱い、元通りに組み直すには、その機種ごとの特性を知り尽くしている必要があります。もし素人が無理に分解しようとしてツメを折ったり、基板を濡らしたりすれば、修理代だけで4〜5万円が飛んでいきます。そんなリスクを冒すよりも、最初からリライフのようなプロにお任せいただくのが、結果として最も賢い選択だと言えます。
リライフが選ばれる理由:
私たちは単に汚れを落とすだけでなく、お客様の大切な資産である家電を長持ちさせるための丁寧な作業を心がけています。無理な洗浄は行わず、機種ごとの最適なアプローチをご提案します。
スプレーで隠さず、「水」で洗い流す
リライフのエアコンクリーニングは、香りでごまかしません。
プロ仕様の高圧洗浄機と大量の水を使用し、
フィンの奥に入り込んだ薬剤成分やカビを徹底的に洗い流します。
使用するのは「植物由来のエコ洗剤」のみ。
小さなお子様やペットがいるご家庭でも安心です。
故障の修理代を払うよりクリーニングの方が安上がり

ここで、自分でスプレーをした場合のリスクと、プロに依頼した場合のコストを比較してみましょう。数百円のスプレーで済ませようとした結果、数万円の修理代がかかっては本末転倒ですよね。
将来への投資としてのクリーニング
定期的なクリーニングを行うことで、エアコンの負荷が減り、電気代の節約にも繋がります。汚れが詰まったままの運転は、設定温度に到達するまでに時間がかかり、コンプレッサーを酷使します。一方、クリーニング後のエアコンは熱交換効率が劇的に向上するため、結果として数年間の電気代差額だけで、クリーニング代が回収できてしまうこともあります。故障のリスクヘッジをしながら節約にもなる、まさに一石二鳥の対策なんです。
| メンテナンス項目 | 費用の目安(税込) | 主なリスク・効果 |
|---|---|---|
| プロの分解洗浄(標準) | 12,000円〜20,000円 | カビを根こそぎ除去。電気代も節約。故障リスク極小。 |
| 市販スプレー(DIY) | 500円〜3,000円 | 故障・火災・カビ悪化のハイリスク。効果は一時的。 |
| 基板交換(故障修理) | 20,000円〜55,000円 | スプレーによるショート・トラッキング修理。高額出費。 |
| 冷媒回路修理(重度) | 80,000円〜130,000円 | フィン腐食によるガス漏れ。買い替えが推奨されるレベル。 |
※数値データはあくまで一般的な目安です。正確な情報は各メーカーの公式サイトをご確認ください。
エアコンの臭いとファブリーズ問題はリライフで解決
いかがでしたでしょうか。エアコンの臭いにファブリーズを使ってしまうことは、一見手軽な解決策に見えて、実は愛用しているエアコンを壊してしまう大きなリスクを孕んでいます。快適な空気を取り戻すために大切なのは、臭いの原因である内部のカビや汚れを、安全に正しく取り除くことです。
私たちリライフでは、お客様の大切な家電を傷つけることなく、プロの技術で隅々までリフレッシュいたします。もし、ご自身での対策に限界を感じたり、火災や故障のリスクが不安になったりした時は、ぜひ一度リライフへご相談ください。誠実な対応と確かな技術で、皆様の健やかな生活をサポートいたします。
プロのクリーニングがもたらす安心感
自分で解決しようと悩んでいる時間は、その分カビを吸い込み続けている時間でもあります。小さなお子様やアレルギーをお持ちの方がいらっしゃるご家庭では、特に早期の根本解決が望まれます。リライフなら、最短当日のお見積りから、スピーディーな施工まで、ストレスなく「あの爽やかな風」を復活させます。エアコンの臭いとファブリーズの使用に関する不安を解消し、安心して深呼吸できる毎日を取り戻しませんか?
お問い合わせをお待ちしております

「うちのエアコン、もう手遅れかな?」「お掃除機能付きだけど大丈夫?」といった些細な疑問でも構いません。まずは私たちのサイトをチェックして、これまでの実績をご覧いただければと思います。最終的な判断はプロの意見を聞いてからでも遅くありません。皆様からのご相談を心よりお待ちしております。
まとめ:正しいエアコンメンテナンス
・ファブリーズなどの布用消臭剤は、故障や火災、カビの悪化を招くため絶対に使わない。
・臭いを感じたら、まずは「16度冷房(窓全開)」のセルフ洗浄を試す。
・それでも解決しない場合は、エアコンクリーニングのプロであるリライフに任せて安全・確実にお掃除する。
免責事項:本記事に掲載されている情報は一般的な知識に基づくものであり、すべての状況における安全性を保証するものではありません。エアコンの不具合や清掃に関する最終的な判断は、メーカーの取扱説明書を確認するか、専門業者にご相談ください。
🍃 深呼吸できるリビングへ
もう、エアコンのニオイに怯える必要はありません。
「変なスプレーを使ってしまったかも…」という不安も、
私たちにすべてお任せください。
プロの洗浄技術で、新品のような澄んだ空気を取り戻します。
まずは現在の状況をお聞かせください。
強引な勧誘は一切ありませんので、お気軽にどうぞ。

コメント